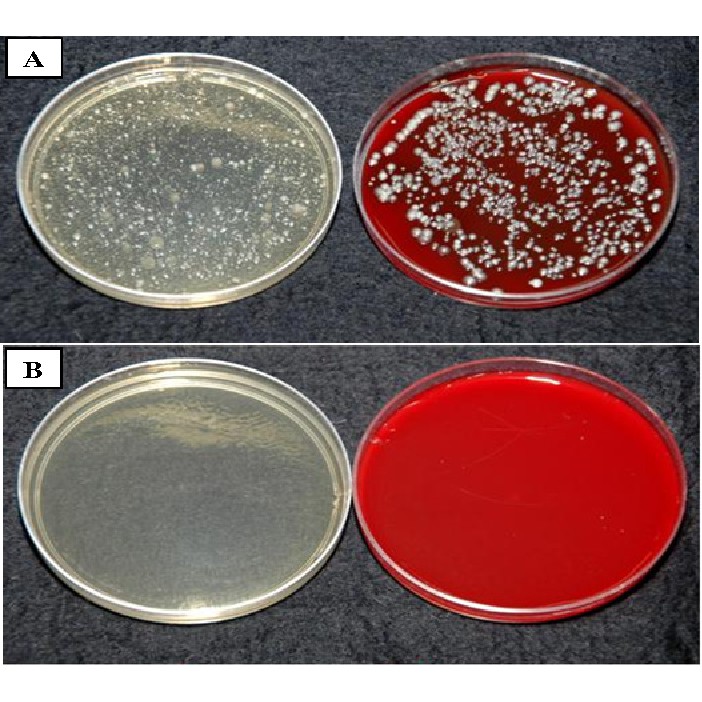
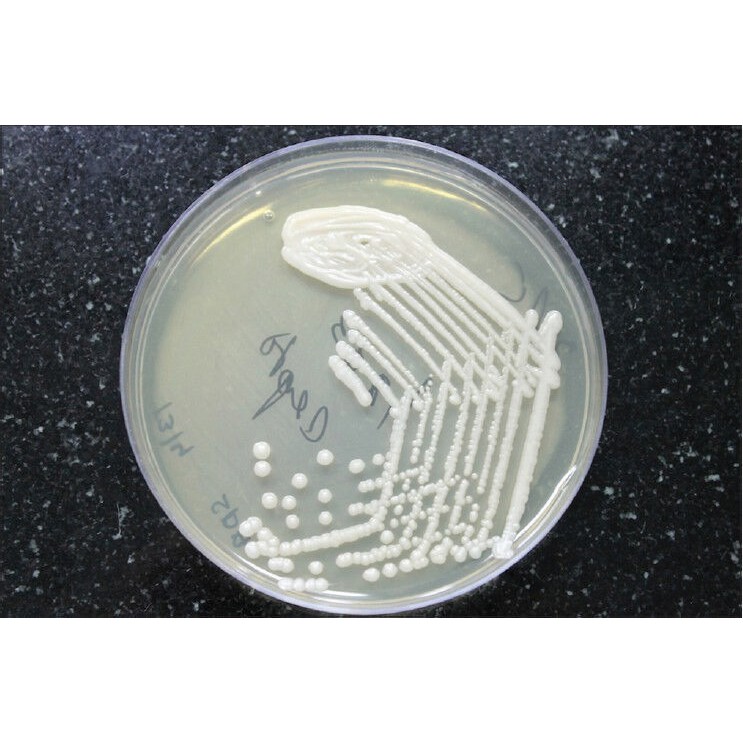

1/5
Lauryl Sulfate Tryptose Broth (Lauryl Tryptose Broth) 160 gram Microbiology Diagnostic Reagent
Guaranteed to get by 13 - 14 Jan, with shipping fee RM0.00 (incl. SST)
Get a RM5.00 voucher if your order arrives late.
15-Day Free Returns · Cash on Delivery · Allergy Protection